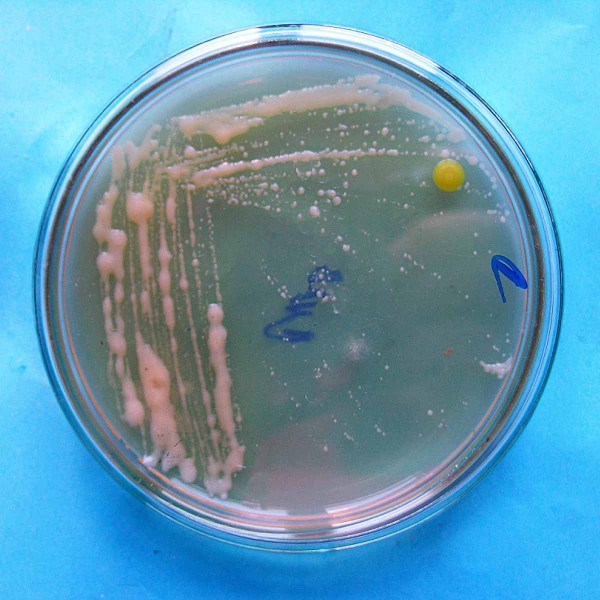
Kolonie bakterie Clavibacter michiganensis subsp. sepedonicus
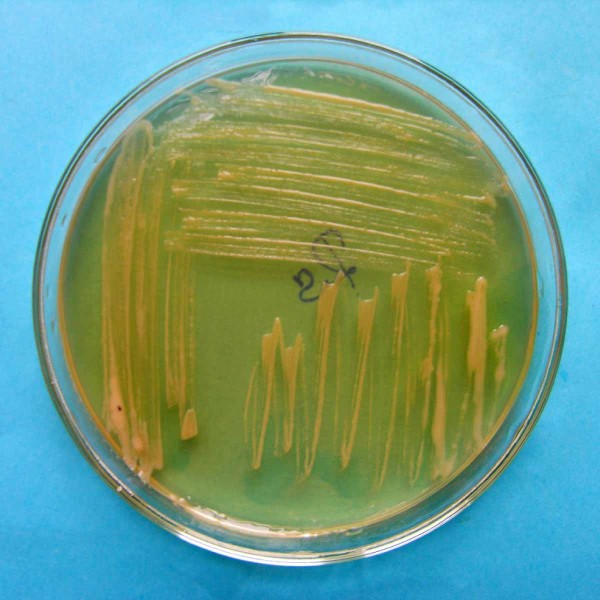
Kolonie bakterie Ralstolnia solanacearum

Choroby bramboru (2): Bakteriální choroby bramboru (I.)
04. 09. 2020 Choroby Zobrazeno 1119x
Bakterie jsou prokaryotní (předjaderné), jednobuněčné organizmy, které u brambor způsobují ztráty na výnosu a snižují kvalitu hlíz. Porost bramboru může být napadán bakteriemi způsobujícími měkké hniloby, strupovitost a vadnutí rostlin. V tomto článku se zaměříme na karanténní bakterie způsobující vadnutí a odumírání rostlin.
Bakteriální kroužkovitost bramboru
Clavibacter michiganensis subsp. sepedonicus je původcem bakteriální kroužkovitosti bramboru. Napadá pouze lilek brambor (Solanum tuberosum), v České republice byl poprvé prokázán v roce 1995.
Příznaky na nadzemních orgánech (slabé vadnutí) se objevují v druhé polovině vegetace, zpravidla až koncem srpna. Listy z napadených trsů jsou zpočátku světle zelené, později pletivo mezi žilkami žloutne, nekrotizuje. Vytváří se okrajová nekróza a lístky se stáčejí podél hlavní žilky směrem nahoru. Příznaky napadení se projevují na nejmladších vrcholových listech. Napadeny mohou být jen některé stonky nebo celý trs. Přítomnost patogena poznáme na příčném řezu stonku, kde můžeme pozorovat zhnědnutí cév. Jelikož viditelné příznaky na nadzemní části rostlin se projevují až ke konci vegetace, můžeme je zaměnit za příznaky jiných chorob či za stárnutí rostliny. Také může docházet k latentním infekcím (bez příznaků), často nepříznivým vlivem vnějších podmínek nebo vlivem nízké koncentrace bakterií v matečné hlíze. Charakteristické příznaky jsou patrné na rozkrojené hlíze, kde můžeme pozorovat krémově žluté až světle hnědé zbarvení cév.
Bakterie Clavibacter michiganensis subsp. sepedonicus je grampozitivní, aerobní, nepohyblivá tyčinka kyjovitého tvaru. Tvoří pomalu rostoucí kolonie v průměru 1–3 mm. Kolonie jsou smetanově bílé, hladké, okrouhlé, vyvýšené s rovnými okraji, slizovitě tekuté.
Patogen přežívá především v infikovaných hlízách, může přežívat také v nerozložených posklizňových zbytcích nebo v infikovaných plevelných rostlinách bramboru. Napadené hlízy jsou nejen zdrojem infekce, ale také se jimi bakterie šíří na velké vzdálenosti. Po výsadbě z napadených hlíz bakterie pronikají vodivými pletivy (xylémem) do nadzemní části rostliny a odtud pak do dceřiných hlíz. Optimální teplota pro růst patogena je 20–23°C.
Bakteriální hnědá hniloba bramboru
Bakterie Ralstolnia solanacearum je heterogenní druh, zahrnuje kmeny s různou biologií a hostitelským okruhem. Je rozšířená zejména v tropech a subtropech, má vysoké teplotní nároky (35–37 °C). Brambory napadá rasa 1 a 3, rasa 3 má nižší teplotní nároky (27 °C). Původcem bakteriální hnědé hniloby bramboru v ČR je Ralstolnia solanacearum rasa 3 biovar 2. Poprvé byla bakterie u nás prokázána v roce 2010, a to ve vzorku závlahové vody z řeky Labe. V roce 2015 byla infekce bakterií zjištěna i u brambor, a to jak konzumních, tak určených pro průmyslové zpracování. V roce 2017 byl výskyt bakterie potvrzen ve vzorcích vody odebraných v řekách Labe, Dyje a Jevišovka a v jednom vzorku hostitelské rostliny lilku potměchuti.
Příznakem je náhlé svinování listů, zpočátku bývá vadnutí přechodné (během noci se turgor obnoví), později však listy a celá rostlina odumírá. Na příčném řezu stonku můžeme pozorovat hnědé zbarvení cév. Charakteristické příznaky jsou patrné na podélném řezu hlízy, prstenec cévních svazků je zpočátku žlutý až světle hnědý a při stisku hlízy vytéká sliz světle krémové barvy. Později se cévní svazky zbarvují hnědě a dochází i k nekróze okolního pletiva.
Bakterie Ralstonia solanacearum je gramnegativní aerobní tyčinka pohyblivá jedním polárním bičíkem. Do rostliny proniká patogen průduchy nebo různými poraněními na stonku a kořenu, uvnitř rostliny se šíří cévními svazky. Hlavní příčinnou vadnutí je osidlování cév bakteriemi, které přilnou ke stěnám cév nebo je zcela vyplní. Vyšší teplota (24–27 °C) a půdní vlhkost je důležitým faktorem, který ovlivňuje množení a přežívání patogenu. Infekce může být i latentní, právě latentně infikované hlízy jsou nejpravděpodobnějším zdrojem infekce a prostředkem k šíření bakterie do nových oblastí. Bakterie může přežívat v plevelných rostlinách, v rostlinných posklizňových zbytcích, v půdě a po dlouhou dobu i ve vodě (záplavová a závlahová voda, odpadní voda), kterou se také šíří na velké vzdálenosti.
Ochrana
Ochrana proti bakteriálním patogenům Clavibacter michiganensis subsp. sepedonicus a Ralstolnia solanacearum spočívá především v prevenci: vysazování zdravých hlíz, dodržování osevního postupu, používání agrotechnických a sanitárních opatření zabraňujících jejich šíření. Nejvýznamnějším preventivním opatřením proti šíření patogenů je systematické testování porostů sadby a sadbových hlíz.

Porovnání příznaků cévního vadnutí na indikátorových rostlinách lilku vejcoplodého infikovaných suspenzí karanténní bakterie Clavibacter sepedonicus o různé koncentraci
Kolonie bakterie Clavibacter michiganensis subsp. sepedonicus

Výron bakteriálního slizu v místě cévních svazků hlízy bramboru infikované karanténní bakterií Ralstonia solanacearum na podélném řezu

Kolaps rostliny rajčete způsobený po infekci karanténní bakterií Ralstonia solanacearum
Kolonie bakterie Ralstolnia solanacearum
Foto: V. Krejzar, J. Víchová
Další články v kategorii Choroby












RSS
RSS